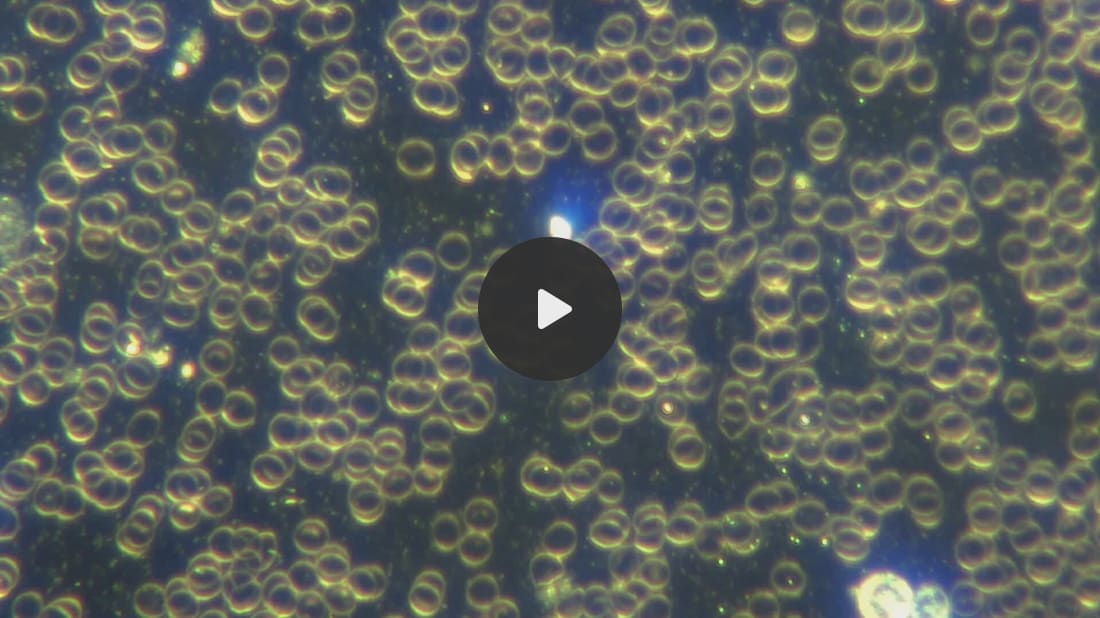

Humanity
is getting another step closer to the Technocratic Transhumanist
Agenda, in which nano and microrobots will not only perform sensing
functions but would have the goal according to Ray Kurzweil, to replace
humans Atom by Atom.
What
is so special about these new robots? They are fully autonomous, have a
full computer system within them and can think for themselves! We know
that science in covert military DARPA projects is much more advanced
then we are led to believe. In fact, if you consider testimony of US
government whistleblowers like deceased engineer Phil Schneider, for
each year after 1944, the black projects have made an estimated progress
of 45 years per year. So the secret government is about 3690 years
advanced in knowledge compared to us. Schneider revealed in the early
2000’s that the periodic table of those secret governments contains 140
elements - ours currently has 118. How would science change if all that
information was released?
I
am mentioning this since the futurists have been predicting what will
happen in our future for decades. This is no longer science fiction, but
even government leaders admit that they can manipulate time, i.e time
travel.
My
point is that what is being revealed in civilian scientific literature
is decades, if not centuries behind what technologies are really
available. The fact that AUTONOMOUS THINKING MICROROBOTS have made it to
the mainstream literature, should give us food for thought.
I
have been showing highly advanced microrobots deployed in COVID19
unvaccinated human blood for several years now - they are fully
autonomous, communicate through light and have swarming capabilities:
Researchers
at the University of Pennsylvania and the University of Michigan have
built the smallest fully programmable autonomous robots ever created.
These microscopic machines can swim through liquid, sense their
surroundings, respond on their own, operate for months at a time, and
cost about one penny each to produce.
Each
robot is barely visible without magnification, measuring roughly 200 by
300 by 50 micrometers. That makes them smaller than a grain of salt.
Because they function at the same scale as many living microorganisms,
the robots could one day help doctors monitor individual cells or assist
engineers in assembling tiny devices used in advanced manufacturing.
Powered
entirely by light, the robots contain microscopic computers that allow
them to follow programmed paths, detect local temperature changes, and
adjust their movement in response.
The work was reported in Science Robotics and Proceedings of the National Academy of Sciences (PNAS).
Unlike previous tiny machines, these robots do not rely on wires,
magnetic fields, or external controls. This makes them the first truly
autonomous and programmable robots at such a small scale.
“We’ve
made autonomous robots 10,000 times smaller,” says Marc Miskin,
Assistant Professor in Electrical and Systems Engineering at Penn
Engineering and the papers’ senior author. “That opens up an entirely
new scale for programmable robots.”
Why shrinking robots has been so difficult
Electronics
have steadily become smaller over the past several decades, but
robotics has not followed the same trajectory. According to Miskin,
independence at sizes below one millimeter has remained an unsolved
challenge. “Building robots that operate independently at sizes below
one millimeter is incredibly difficult,” he says. “The field has
essentially been stuck on this problem for 40 years.”
At
everyday scales, motion is shaped by forces such as gravity and
inertia, which depend on an object’s volume. At microscopic sizes,
however, surface-related forces dominate instead. Drag and viscosity
become overwhelming, dramatically changing how movement works. “If
you’re small enough, pushing on water is like pushing through tar,” says
Miskin.
Because
of this shift in physics, conventional robotic designs fail. Small arms
or legs tend to break easily and are extremely difficult to
manufacture. “Very tiny legs and arms are easy to break,” Miskin
explains. “They’re also very hard to build.”
To
overcome these limitations, the researchers developed a completely new
way for robots to move that works with the physics of the microscopic
world rather than fighting against it.
How microscopic robots swim
Fish
and other large swimmers move by pushing water backward, generating
forward motion through Newton’s Third Law. The tiny robots take a very
different approach.
Instead
of bending or flexing, the robots generate an electrical field that
gently pushes charged particles in the surrounding liquid. As those ions
move, they drag nearby water molecules with them, effectively creating
motion in the fluid around the robot. “It’s as if the robot is in a
moving river,” says Miskin, “but the robot is also causing the river to
move.”
By
adjusting this electrical field, the robots can change direction,
follow complex paths, and even coordinate their movement in groups that
resemble schools of fish. They can reach speeds of up to one body length
per second.
Because
this swimming method uses electrodes with no moving parts, the robots
are remarkably durable. According to Miskin, they can be transferred
between samples repeatedly with a micropipette without damage. Powered
by light from an LED, the robots are able to keep swimming for months.
Packing intelligence into a microscopic body
True
autonomy requires more than movement. A robot must also be able to
sense its environment, make decisions, and power itself. All of those
components must fit onto a chip that is only a fraction of a millimeter
across. This challenge was taken on by David Blaauw’s team at the
University of Michigan.
Blaauw’s
lab already holds the record for creating the world’s smallest
computer. When Blaauw and Miskin met at a Defense Advanced Research
Projects Agency (DARPA) presentation five years ago, they quickly
realized their technologies complemented each other. “We saw that Penn
Engineering’s propulsion system and our tiny electronic computers were
just made for each other,” says Blaauw. Even so, turning that idea into a
working robot required five years of development.
One
of the biggest obstacles was power. “The key challenge for the
electronics,” Blaauw says, “is that the solar panels are tiny and
produce only 75 nanowatts of power. That is over 100,000 times less
power than what a smart watch consumes.” To make the system work, the
team designed specialized circuits that operate at extremely low
voltages, cutting power consumption by more than 1000 times.
Space
was another major constraint. The solar panels take up most of the
robot’s surface, leaving very little room for computing hardware. To
solve this, the researchers redesigned how the robot’s software works.
“We had to totally rethink the computer program instructions,” Blaauw
explains, “condensing what conventionally would require many
instructions for propulsion control into a single, special instruction
to shrink the program’s length to fit in the robot’s tiny memory space.”
Robots that sense and communicate
Together,
these advances produced what the researchers believe is the first
sub-millimeter robot capable of real decision-making. To their
knowledge, no one has previously placed a complete computer with a
processor, memory, and sensors into a robot this small. That achievement
allows the robots to sense their environment and respond independently.
The
robots include electronic temperature sensors that can detect changes
as small as one third of a degree Celsius. This capability allows them
to move toward warmer regions or report temperature values that can
serve as indicators of cellular activity, offering a way to monitor
individual cells.
Communicating
those measurements required an inventive solution. “To report out their
temperature measurements, we designed a special computer instruction
that encodes a value, such as the measured temperature, in the wiggles
of a little dance the robot performs,” says Blaauw. “We then look at
this dance through a microscope with a camera and decode from the
wiggles what the robots are saying to us. It’s very similar to how honey
bees communicate with each other.”
The
same light that powers the robots is also used to program them. Each
robot has a unique address, allowing researchers to upload different
instructions to different units. “This opens up a host of
possibilities,” Blaauw adds, “with each robot potentially performing a
different role in a larger, joint task.”
A platform for future microscopic machines
The
current robots are only the starting point. Future versions could carry
more advanced programs, move faster, include additional sensors, or
function in harsher environments. The researchers designed the system as
a flexible platform, combining a robust propulsion method with
electronics that can be manufactured cheaply and adapted over time.
“This
is really just the first chapter,” says Miskin. “We’ve shown that you
can put a brain, a sensor and a motor into something almost too small to
see, and have it survive and work for months. Once you have that
foundation, you can layer on all kinds of intelligence and
functionality. It opens the door to a whole new future for robotics at
the microscale.”

No comments:
Post a Comment